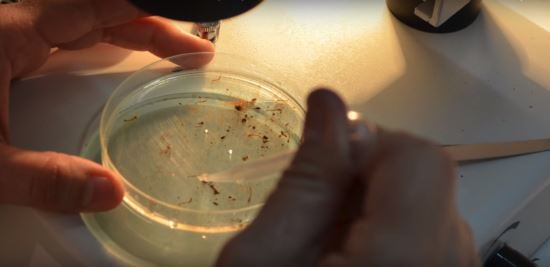

[쿠키뉴스=박예슬 기자] 전 세계적으로 관심이 고조되고 있는 지카바이러스가 우간다의 원숭이에서 최초로 발견됐다.
지카바이러스는 1974년 아프리카 우간다의 지카 숲에 살고 있는 히말라야 원숭이의 혈액에서 검출된 신종 바이러스라고 해서 ‘지카바이러스’라고 불리게 된 것이다.
이후 1950년에 들어 사람도 지카바이러스에 감염될 수 있다는 사실이 확인됐다. 중앙아프리카공화국, 이집트, 탄자니아 등 아프리카의 여러 나라를 비롯해, 1970년대에는 동남아시아 지역으로 건너가 인도, 말레이시아, 인도네시아 등에서 발생하기 시작했다.
최근 들어 2013년 남태평양 타히티섬에서 발생했고, 2014년에는 브라질에서 100만명 이상이 지카바이러스에 감염된 것으로 나타났는데 당시 열리는 월드컵 대회에 많은 사람들이 방문하며 유입된 것으로 추정하고 있다.
또한 2009년에는 모기 연구를 위해 세네갈을 방문했던 한 생물학자는 성적 접촉으로 인해 그의 아내에게 지카바이러스를 전파해, 성적접촉으로 인해 감염된 사례로 알려져 있다.
지카바이러스의 주요 감염경로는 이집트 숲모기를 포함한 숲모기의 종들이다. 이 모기들은 주로 아프리카, 남태평양, 중남미 등 열대성 지역에 서식하는 것이 특징이다. 영국 보건부 관계자에 따르면 이집트 숲모기에 물리지 않는 이상 기본적으로 사람 간 전염은 안 된다고 밝힌 바 있다.
이처럼 지카바이러스는 중남미에서 서식하는 모기에 의해 감염되는 것으로 알려져, 중남미 지역을 다녀온 사람들에 한해 감염 가능성이 있는 것으로 보았다. 그러나 최근 중남미에 다녀온 적이 없는 대만 남성이 지카바이러스에 감염돼, 다른 감염경로가 있을 것으로 추정된다. 이에 대만 보건당국은 현재 해당 남성의 감염경로 추적에 나선 상태다.
현재 지카바이러스에 대한 예방 백신은 따로 없기 때문에 중남미에 가지 않는 것이 최선책이다. 그러나 만약 모기 외에 다른 감염경로가 있다면 상황이 달라진다. 빠른 시일 내에 추가 감염경로가 밝혀지는 대로 감염확산에 대비해야 할 것으로 보인다. yes228@kukimedia.co.kr
[쿠키영상] ‘도도맘’ 김미나, 강제추행으로 지인 고소...신동욱 "'미인대박'으로 거듭 태어나길"
[쿠키영상] 불후의 클래식 57곡을 믹스한 '역대급' 명곡?
[쿠키영상] '남성들 선망의 직업'…모델 전문 마사지사의 한탄










